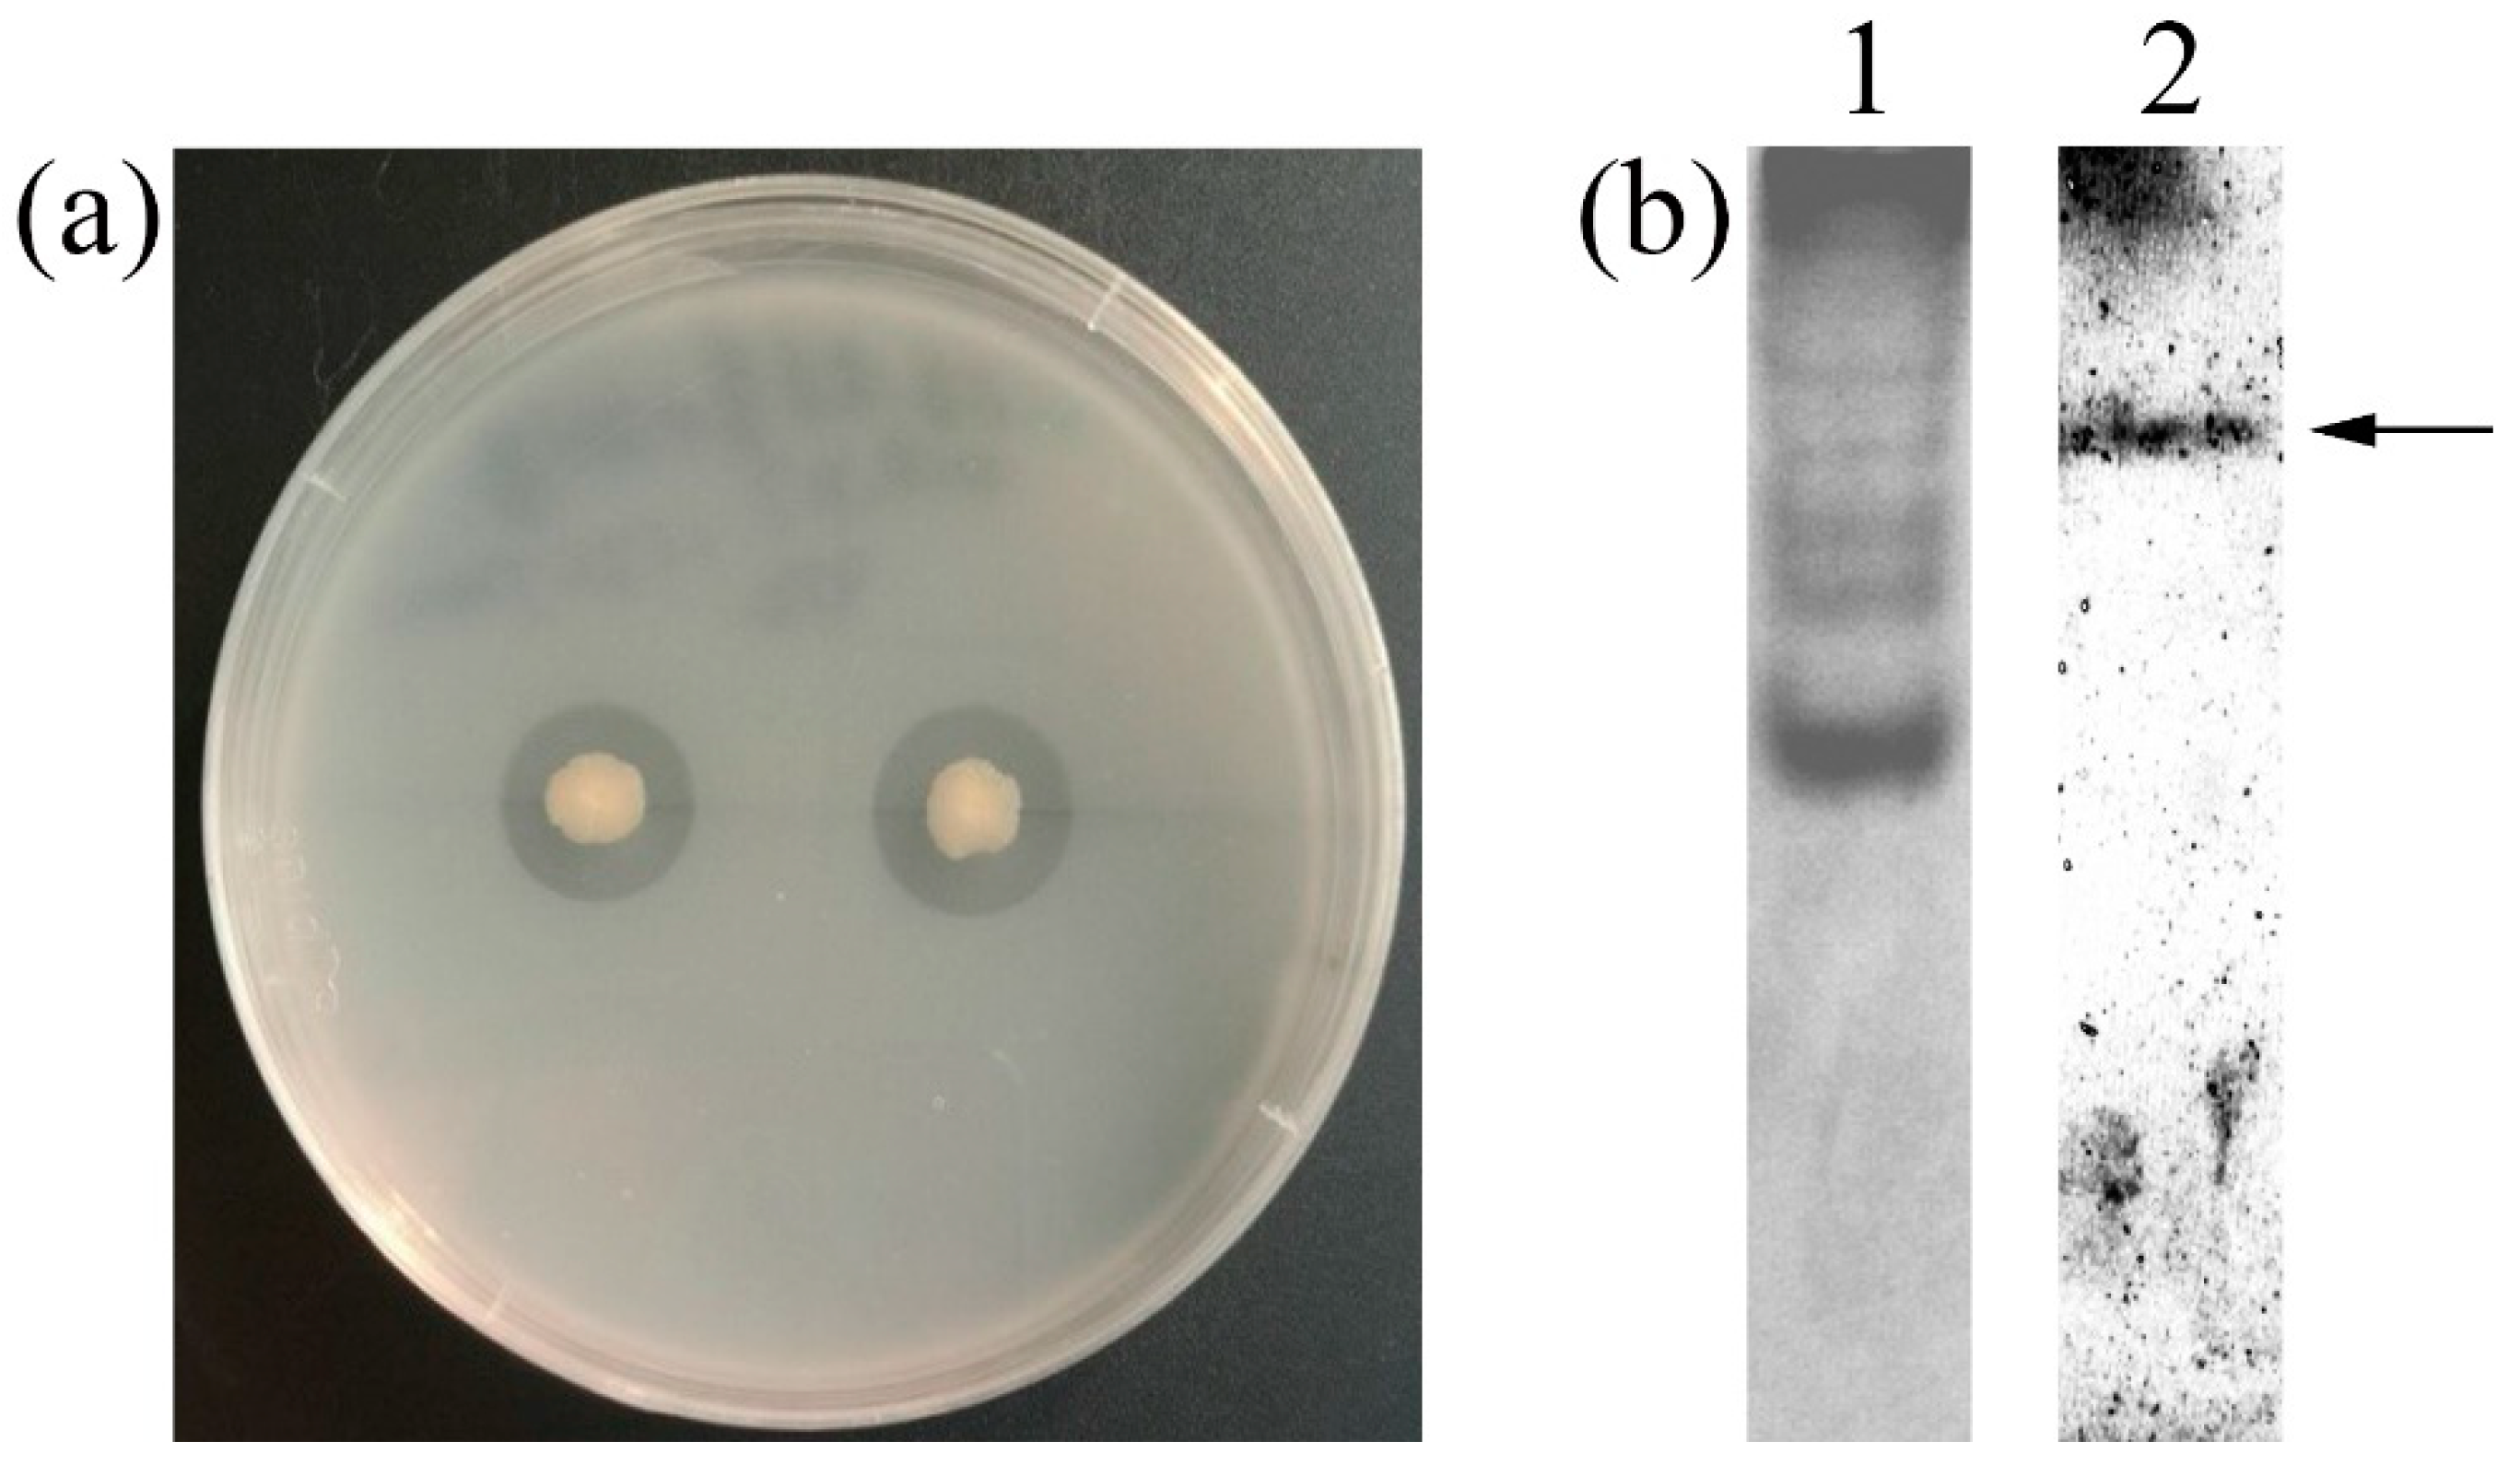
Marinedrugs 17 00695 g001 Marinedrugs 17 00695 g001
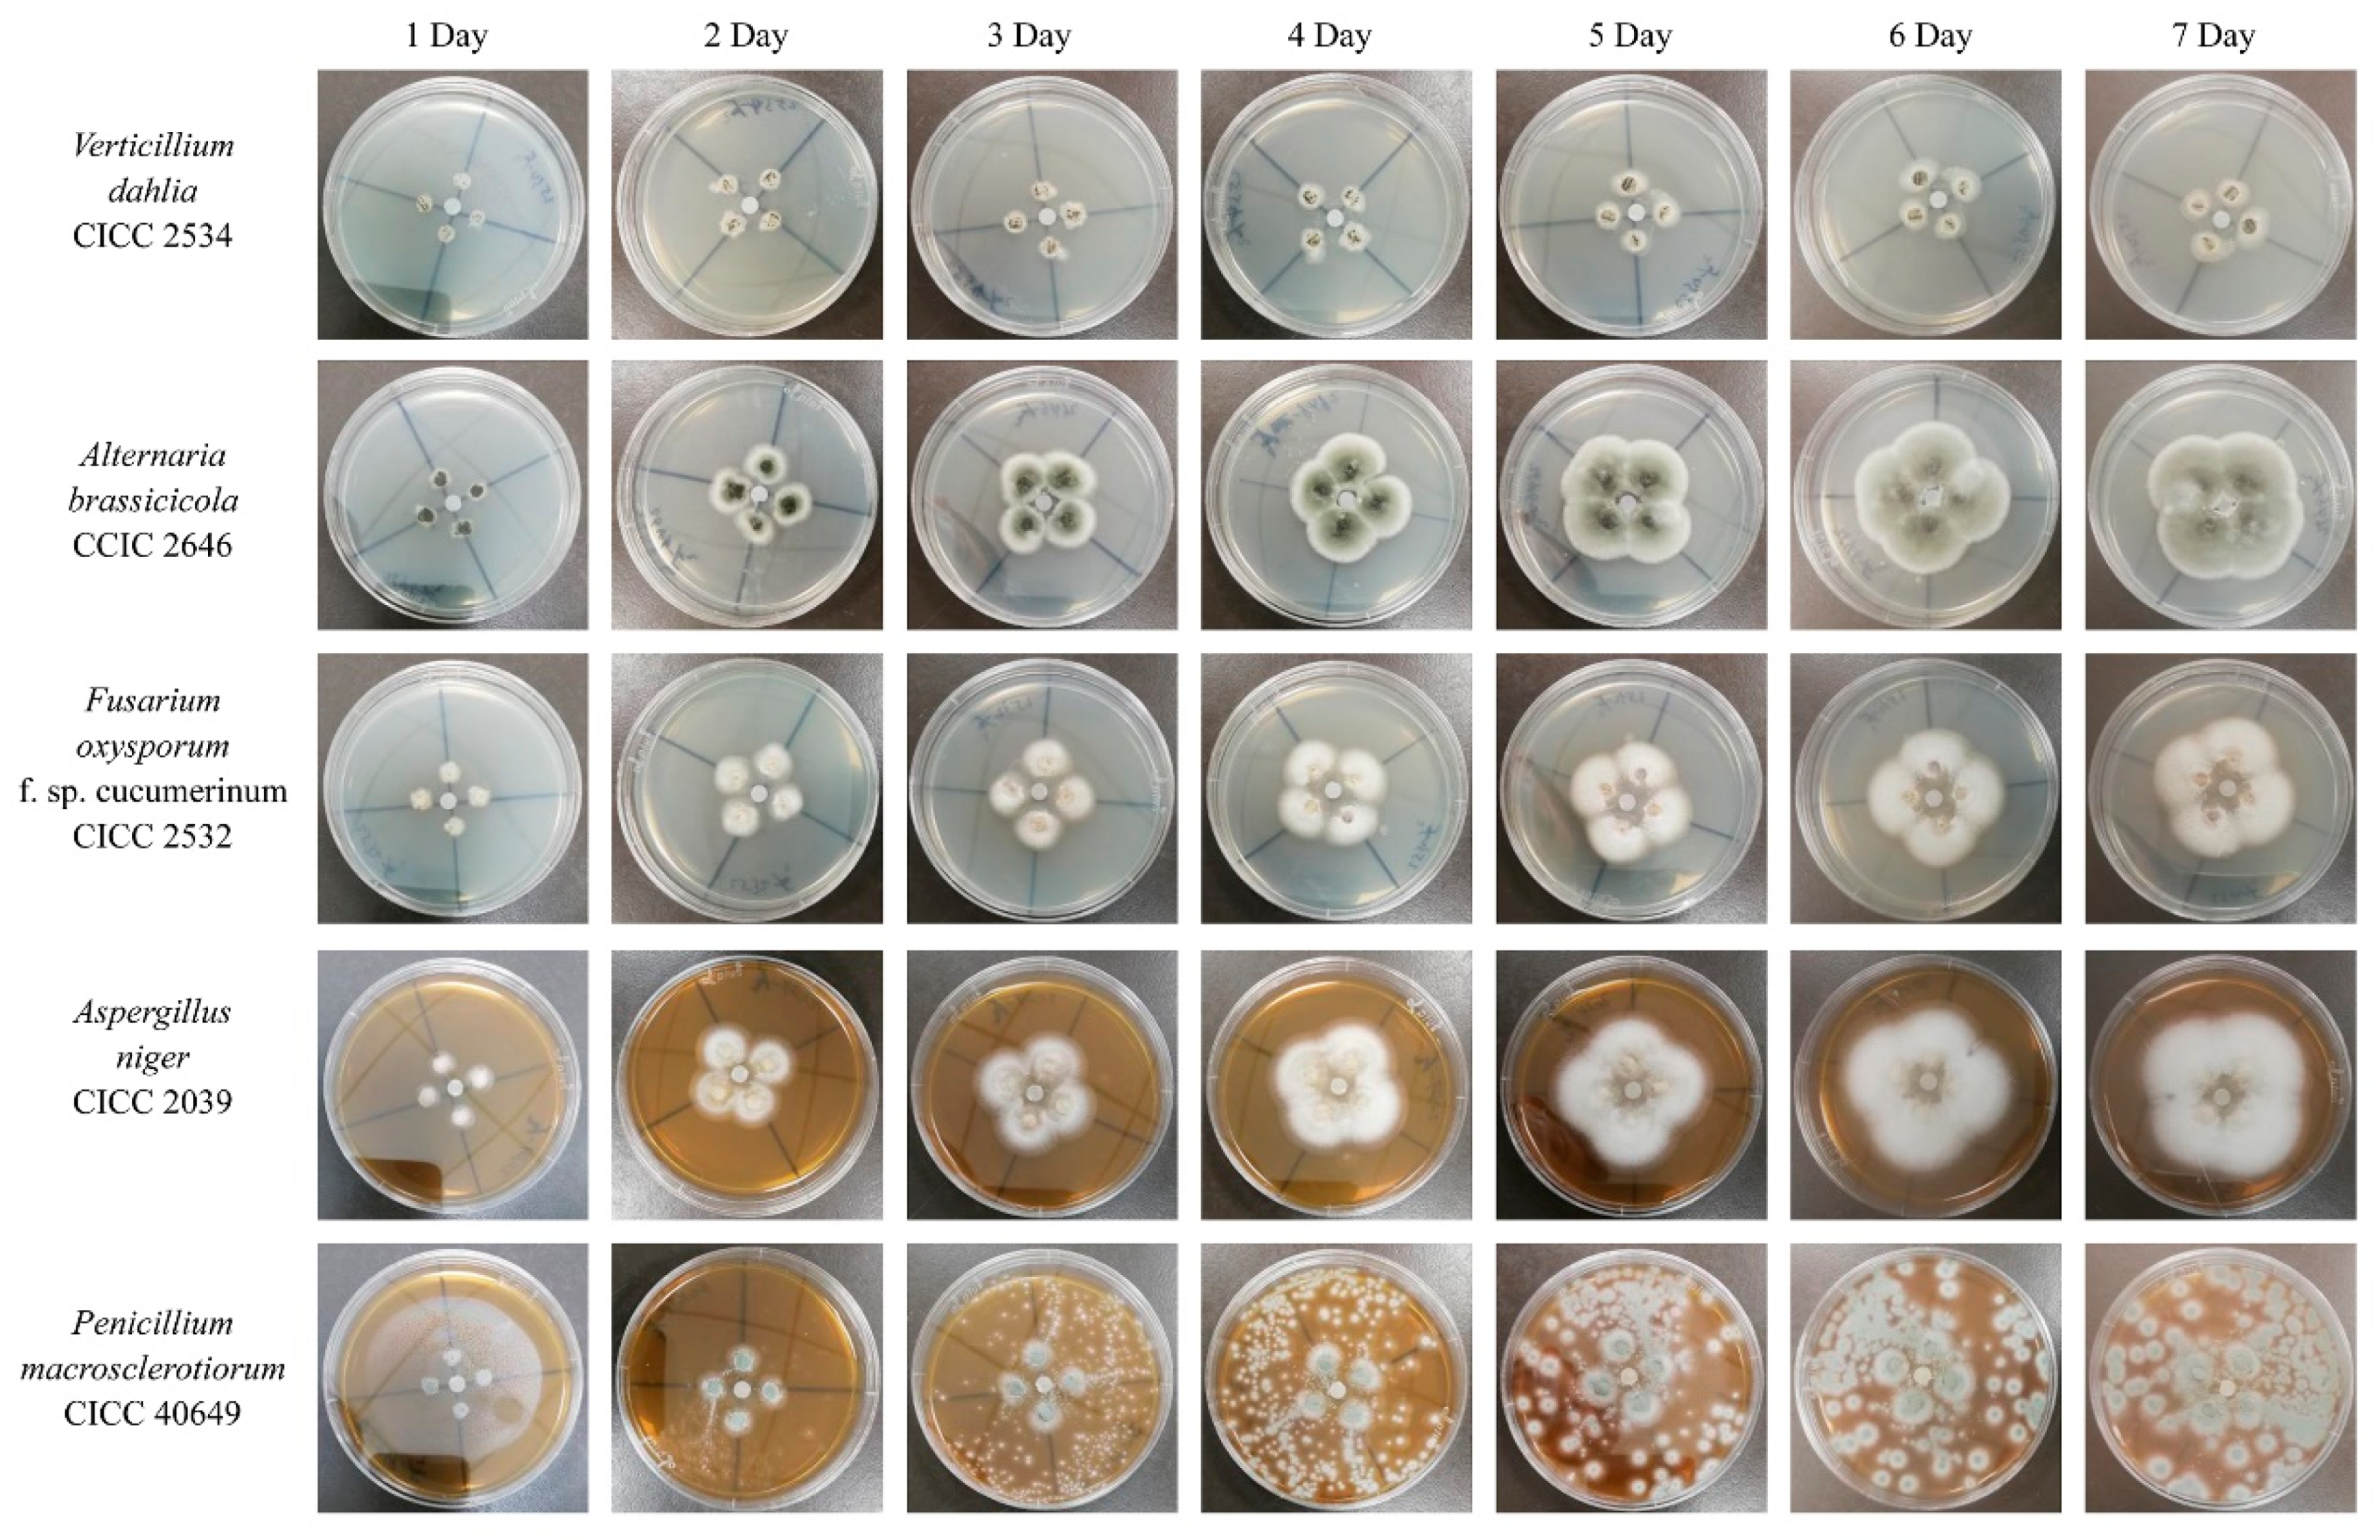
Marinedrugs 17 00695 g006 Marinedrugs 17 00695 g006

A Cold-Adapted Chitinase-Producing Bacterium from Antarctica and Its Potential in Biocontrol of Plant Pathogenic Fungi
Abstract
1. Introduction
2. Results
2.1. Screening, Isolation and Identification of the Chitinase-Producing Bacterium
2.2. One-Factor-at-a-Time Optimization
2.3. Orthogonal Design
2.4. Temperature and pH-Dependent Enzymatic Properties of Chitinase
2.5. Antifungal Activity
3. Discussion
4. Materials and Methods
4.1. Chemicals, Agents and Media
4.2. Screening and Characterization of Chitinase-Producing Microorganisms
4.3. Preparation of Crude Chitinase
4.4. Native-PAGE and Active Staining of Chitinase
4.5. Chitinase Activity Assay
4.6. One-Factor-at-a-Time Optimization
4.7. Orthogonal Design
4.8. Temperature and pH-Dependent Enzymatic Properties of Crude Chitinase
4.9. Antifungal Activity Assay
5. Conclusions
Author Contributions
Funding
Conflicts of Interest
References
- Moussian, B. Chitin: Structure, Chemistry and Biology. Adv. Exp. Med. Biol. 2019, 1142, 5–18. [Google Scholar] [PubMed]
- Guan, G.; Azad, M.A.K.; Lin, Y.; Kim, S.W.; Tian, Y.; Liu, G.; Wang, H. Biological Effects and Applications of Chitosan and Chito-Oligosaccharides. Front. Physiol. 2019, 10, 516. [Google Scholar] [CrossRef] [PubMed]
- Schmitz, C.; Auza, L.G.; Koberidze, D.; Rasche, S.; Fischer, R.; Bortesi, L. Conversion of Chitin to Defined Chitosan Oligomers: Current Status and Future Prospects. Mar. Drugs 2019, 17, 452. [Google Scholar] [CrossRef] [PubMed]
- Jung, W.J.; Park, R.D. Bioproduction of chitooligosaccharides: Present and perspectives. Mar. Drugs 2014, 12, 5328–5356. [Google Scholar] [CrossRef] [PubMed]
- Le, B.; Yang, S.H. Microbial chitinases: Properties, current state and biotechnological applications. World J. Microbiol. Biotechnol. 2019, 35, 144. [Google Scholar] [CrossRef] [PubMed]
- Bhattacharya, D.; Nagpure, A.; Gupta, R.K. Bacterial chitinases: Properties and potential. Crit. Rev. Biotechnol. 2007, 27, 21–28. [Google Scholar] [CrossRef]
- Hartl, L.; Zach, S.; Seidl-Seiboth, V. Fungal chitinases: Diversity, mechanistic properties and biotechnological potential. Appl. Microbiol. Biotechnol. 2012, 93, 533–543. [Google Scholar] [CrossRef]
- Volpicella, M.; Leoni, C.; Fanizza, I.; Placido, A.; Pastorello, E.A.; Ceci, L.R. Overview of plant chitinases identified as food allergens. J. Agric. Food Chem. 2014, 62, 5734–5742. [Google Scholar] [CrossRef]
- Arakane, Y.; Muthukrishnan, S. Insect chitinase and chitinase-like proteins. Cell. Mol. Life Sci. 2010, 67, 201–216. [Google Scholar] [CrossRef]
- Kumar, A.; Zhang, K.Y.J. Human Chitinases: Structure, Function, and Inhibitor Discovery. Adv. Exp. Med. Biol. 2019, 1142, 221–251. [Google Scholar]
- Neeraja, C.; Anil, K.; Purushotham, P.; Suma, K.; Sarma, P.; Moerschbacher, B.M.; Podile, A.R. Biotechnological approaches to develop bacterial chitinases as a bioshield against fungal diseases of plants. Crit. Rev. Biotechnol. 2010, 30, 231–241. [Google Scholar] [CrossRef] [PubMed]
- Han, S.J.; Park, H.; Lee, S.G.; Lee, H.K.; Yim, J.H. Optimization of cold-active chitinase production from the Antarctic bacterium, Sanguibacter antarcticus KOPRI 21702. Appl. Microbiol. Biotechnol. 2011, 89, 613–621. [Google Scholar] [CrossRef] [PubMed]
- Mishra, P.; Kshirsagar, P.R.; Nilegaonkar, S.S.; Singh, S.K. Statistical optimization of medium components for production of extracellular chitinase by Basidiobolus ranarum: A novel biocontrol agent against plant pathogenic fungi. J. Basic Microbiol. 2012, 52, 539–548. [Google Scholar] [CrossRef] [PubMed]
- Tasharrofi, N.; Adrangi, S.; Fazeli, M.; Rastegar, H.; Khoshayand, M.R.; Faramarzi, M.A. Optimization of Chitinase Production by Bacillus pumilus Using Plackett-Burman Design and Response Surface Methodology. Iran. J. Pharm. Res. 2011, 10, 759–768. [Google Scholar]
- Hao, Z.; Cai, Y.; Liao, X.; Zhang, X.; Fang, Z.; Zhang, D. Optimization of nutrition factors on chitinase production from a newly isolated Chitiolyticbacter meiyuanensis SYBC-H1. Braz. J. Microbiol. 2012, 43, 177–186. [Google Scholar] [CrossRef]
- Singh, A.K.; Mehta, G.; Chhatpar, H.S. Optimization of medium constituents for improved chitinase production by Paenibacillus sp. D1 using statistical approach. Lett. Appl. Microbiol. 2009, 49, 708–714. [Google Scholar] [CrossRef]
- Xia, J.L.; Xiong, J.; Zhang, R.Y.; Liu, K.K.; Huang, B.; Nie, Z.Y. Production of Chitinase and its Optimization from a Novel Isolate Serratia marcescens XJ-01. Indian J. Microbiol. 2011, 51, 301–306. [Google Scholar] [CrossRef]
- Narayana, K.J.; Vijayalakshmi, M. Chitinase Production by Streptomyces sp. ANU 6277. Braz. J. Microbiol. 2009, 40, 725–733. [Google Scholar] [CrossRef]
- Singh, R.K.; Kumar, D.P.; Solanki, M.K.; Singh, P.; Srivastva, A.K.; Kumar, S.; Kashyap, P.L.; Saxena, A.K.; Singhal, P.K.; Arora, D.K. Optimization of media components for chitinase production by chickpea rhizosphere associated Lysinibacillus fusiformis B-CM18. J. Basic Microbiol. 2013, 53, 451–460. [Google Scholar] [CrossRef]
- Meriem, G.; Mahmoud, K. Optimization of chitinase production by a new Streptomyces griseorubens C9 isolate using response surface methodology. Ann. Microbiol. 2017, 67, 175–183. [Google Scholar] [CrossRef]
- Shivalee, A.; Lingappa, K.; Mahesh, D. Influence of bioprocess variables on the production of extracellular chitinase under submerged fermentation by Streptomyces pratensis strain KLSL55. J. Genet. Eng. Biotechnol. 2018, 16, 421–426. [Google Scholar] [CrossRef] [PubMed]
- Kumar, M.; Brar, A.; Vivekanand, V.; Pareek, N. Production of chitinase from thermophilic Humicola grisea and its application in production of bioactive chitooligosaccharides. Int. J. Biol. Macromol. 2017, 104, 1641–1647. [Google Scholar] [CrossRef] [PubMed]
- Aliabadi, N.; Aminzadeh, S.; Karkhane, A.A.; Haghbeen, K. Thermostable chitinase from Cohnella sp. A01: Isolation and product optimization. Braz. J. Microbiol. 2016, 47, 931–940. [Google Scholar] [CrossRef] [PubMed]
- Wang, K.; Yan, P.S.; Cao, L.X. Chitinase from a novel strain of Serratia marcescens JPP1 for biocontrol of aflatoxin: Molecular characterization and production optimization using response surface methodology. BioMed Res. lnt. 2014, 2014, 482623. [Google Scholar]
- Khan, M.A.; Hamid, R.; Ahmad, M.; Abdin, M.Z.; Javed, S. Optimization of culture media for enhanced chitinase production from a novel strain of Stenotrophomonas maltophilia using response surface methodology. J. Microbiol. Biotechnol. 2010, 20, 1597–1602. [Google Scholar] [CrossRef]
- Siddiqui, K.S. Some like it hot, some like it cold: Temperature dependent biotechnological applications and improvements in extremophilic enzymes. Biotechnol. Adv. 2015, 33, 1912–1922. [Google Scholar] [CrossRef]
- Bruno, S.; Coppola, D.; di Prisco, G.; Giordano, D.; Verde, C. Enzymes from Marine Polar Regions and Their Biotechnological Applications. Mar. Drugs 2019, 17, 544. [Google Scholar] [CrossRef]
- Yoon, S.H.; Ha, S.M.; Kwon, S.; Lim, J.; Kim, Y.; Seo, H.; Chun, J. Introducing EzBioCloud: A taxonomically united database of 16S rRNA gene sequences and whole-genome assemblies. Int. J. Syst. Evol. Microbiol. 2017, 67, 1613–1617. [Google Scholar]
- Bozal, N.; Montes, M.J.; Mercade, E. Pseudomonas guineae sp. nov., a novel psychrotolerant bacterium from an Antarctic environment. Int. J. Syst. Evol. Microbiol. 2007, 57, 2609–2612. [Google Scholar] [CrossRef]
- Rabbani, G.; Ahmad, E.; Khan, M.V.; Ashraf, M.T.; Bhat, R.; Khan, R.H. Impact of structural stability of cold adapted Candida antarctica lipase B (CaLB): In relation to pH, chemical and thermal denaturation. RSC Adv. 2015, 5, 20115–20131. [Google Scholar] [CrossRef]
- Andronopoulou, E.; Vorgias, C.E. Multiple components and induction mechanism of the chitinolytic system of the hyperthermophilic archaeon Thermococcus chitonophagus. Appl. Microbiol. Biotechnol. 2004, 65, 694–702. [Google Scholar] [CrossRef] [PubMed]
- Nawani, N.N.; Kapadnis, B.P.; Das, A.D.; Rao, A.S.; Mahajan, S.K. Purification and characterization of a thermophilic and acidophilic chitinase from Microbispora sp. V2. J. Appl. Microbiol. 2002, 93, 965–975. [Google Scholar] [CrossRef] [PubMed]
- St Leger, R.J.; Cooper, R.M.; Charnley, A.K. Cuticle-degrading Enzymes of Entomopathogenic Fungi: Regulation of Production of Chitinolytic Enzymes. Microbiology 1986, 132, 1509–1517. [Google Scholar] [CrossRef][Green Version]
- Souza, C.P.; Burbano-Rosero, E.M.; Almeida, B.C.; Martins, G.G.; Albertini, L.S.; Rivera, I.N.G. Culture medium for isolating chitinolytic bacteria from seawater and plankton. World J. Microbiol. Biotechnol. 2009, 25, 2079–2082. [Google Scholar] [CrossRef]
- Larkin, M.A.; Blackshields, G.; Brown, N.P.; Chenna, R.; McGettigan, P.A.; McWilliam, H.; Valentin, F.; Wallace, I.M.; Wilm, A.; Lopez, R.; et al. Clustal W and Clustal X version 2.0. Bioinformatics 2007, 23, 2947–2948. [Google Scholar] [CrossRef]
- Saitou, N.; Nei, M. The neighbor-joining method: A new method for reconstructing phylogenetic trees. Mol. Biol. Evol. 1987, 4, 406–425. [Google Scholar]
- Tamura, K.; Stecher, G.; Peterson, D.; Filipski, A.; Kumar, S. MEGA6: Molecular Evolutionary Genetics Analysis version 6.0. Mol. Biol. Evol. 2013, 30, 2725–2729. [Google Scholar] [CrossRef]
- Trudel, J.; Asselin, A. Detection of chitinase activity after polyacrylamide gel electrophoresis. Anal. Biochem. 1989, 178, 362–366. [Google Scholar] [CrossRef]
- Imoto, T.; Yagishita, K. A Simple Activity Measurement of Lysozyme. Agric. Biol. Chem. 1971, 35, 1154–1156. [Google Scholar] [CrossRef]
- Rabbani, G.; Ahmad, E.; Zaidi, N.; Fatima, S.; Khan, R.H. pH-Induced molten globule state of Rhizopus niveus lipase is more resistant against thermal and chemical denaturation than its native state. Cell Biochem. Biophys. 2012, 62, 487–499. [Google Scholar] [CrossRef]

| No. | (A) Glucose (g L−1) | (B) Peptone (g L−1) | (C) Chitin (g L−1) | (D) Mg2+ (mM) | Chitinolytic Activity (U L−1) |
|---|---|---|---|---|---|
| 1 | 5 | 1 | 5 | 1 | 52.25 ± 3.73 |
| 2 | 5 | 2 | 10 | 5 | 16.17 ± 2.16 |
| 3 | 5 | 3 | 15 | 10 | 22.64 ± 6.26 |
| 4 | 10 | 1 | 10 | 10 | 18.66 ± 3.73 |
| 5 | 10 | 2 | 15 | 1 | 51.01 ± 2.15 |
| 6 | 10 | 3 | 5 | 5 | 7.46 ± 6.47 |
| 7 | 15 | 1 | 15 | 5 | 72.16 ± 7.77 |
| 8 | 15 | 2 | 5 | 10 | 37.32 ± 3.73 |
| 9 | 15 | 3 | 10 | 1 | 6.22 ± 2.16 |
| K1 | 91.07 | 143.08 | 97.04 | 109.49 | |
| K2 | 77.14 | 104.51 | 41.06 | 95.80 | |
| K3 | 115.71 | 36.33 | 145.81 | 78.63 | |
| k1 | 30.36 | 47.69 | 32.35 | 36.50 | |
| k2 | 25.71 | 34.84 | 13.69 | 31.93 | |
| k3 | 38.57 | 12.11 | 48.60 | 26.21 | |
| Range | 12.86 | 35.58 | 34.91 | 10.29 | |
| Factor order | B > C > A > D | ||||
| Optimization combination | A3 | B1 | C3 | D1 | |
| Source | Sum of Square | Degrees of Freedom | Mean Square | F-value | p-value |
|---|---|---|---|---|---|
| Glucose | 762.85 | 2 | 381.42 | 17.42 | <0.01 |
| Peptone | 5843.69 | 2 | 2921.84 | 133.43 | <0.01 |
| Chitin | 5495.72 | 2 | 2747.86 | 125.49 | <0.01 |
| Mg2+ | 478.03 | 2 | 239.02 | 10.92 | <0.01 |
| Error | 394.16 | 18 | 21.90 | ||
| Total | 39843.59 | 27 |
| Strains | Source | Method | Component a (g L−1) | Condition | Yield (Final/ Initial) |
|---|---|---|---|---|---|
| Pseudomonas sp. GWSMS-1 (this study) | Sediments, Antarctic | OFAT OD | Colloidal chitin: 15.0 Glucose: 15.0 Peptone: 1.0 MgSO4·7H2O: 0.25 KH2PO4: 0.3 K2HPO4·3H2O: 1.0 | Temperature: 20 °C pH: 7.0 Rotary speed: 150 rpm Time: 6 days | 6.36 |
| Sanguibacter antarcticus KOPRI 21702 [12] | Sea sand, Antarctic | OFAT PBD RSM | Chitin: 2.0 Glycerol: 10.0 Peptone: 5.0 Yeast extract: 1.0 Fe(C6H5O7): 0.01 NaCl: 23.0 MgCl2: 2.5 Na2SO4: 3.24 CaCl2: 1.8 NaHCO3: 0.16 | Temperature: 25 °C pH: 6.5 DO: 30% Time: 3 days | 7.5 |
| Basidiobolus ranarum [13] | Frog excrement | RSM | Colloidal chitin: 15 Lactose: 1.25 Malt extract: 0.25 Peptone: 0.75 | Temperature: 25 °C pH: 9.0 Rotary speed: 200 rpm Time: 5 days | 7.71 |
| Bacillus pumilus U5 [14] | Soil, Iran | PBD RSM | Chitin: 4.760 Yeast extract: 0.439 MgSO4⋅7H2O: 0.0055 FeSO4⋅7H2O: 0.019 | Temperature: 30 °C pH: 6.5 Rotary speed: 150 rpm Time: 8 days | 1.20 |
| Chitinolyticbacter meiyuanensis SYBC-H1 [15] | Soil, China | PBD RSM | Chitin: 3.8 Inulin: 3.55 Urea: 3.1 (NH4)2SO4: 0.64 MgSO4·7H2O: 0.5 FeSO4·7H2O: 0.02 KH2PO4: 0.7 K2HPO4: 0.3 | Temperature: 30 °C pH: 7.0 Rotary speed: 200 rpmTime: 4 days | 15.5 |
| Paenibacillus sp. D1 [16] | Effluent, India | PBD RSM | Chitin: 3.75 Yeast extract: 0.6 5Urea: 0.33 MgSO4: 0.30 K2HPO4: 1.17 | Temperature: 30 °C pH: 7.2 Rotary speed: 180 rpm Time: 3 days | 2.56 |
| Serratia Marcescens XJ-01 [17] | Fishing field, China | OFA TOD | Colloidal chitin: 7.5 (NH4)2SO4: 5 MgSO4⋅7H2O: 0.5 KH2PO4: 2.4 K2HPO4·3H2O: 0.6 | Temperature: 32 °C pH: 8.0 Rotary speed: 180 rpm Time: 32 h | N.M. c |
| Streptomyces sp. ANU 6277 [18] | Soil, India | OFAT | Colloidal chitin: 10.0 Starch: 2.0 Yeast extract: 4.0 KH2PO4: 2 MgSO4⋅7H2O: 1 FeSO4·7H2O: 0.1 | Temperature: 35 °C pH: 6.0 Time: 2.5 days | N.M. |
| Lysinibacillus fusiformis B-CM18 [19] | Chickpea rhizosphere | OFAT RSM | Colloidal chitin: 5.50 Starch: 0.55 Yeast extract: 0.55 NaCl: 4.5 NH4Cl: 1.0 CaCl2: 0.1 MgSO4: 0.12 KH2PO4: 3.0 Na2HPO4: 6.0 | Temperature: 32.5 °C pH: 7.0 Rotary speed: 150 rpm Time: 2–5 days | 56.1 |
| Streptomyces griseorubens C9 [20] | Soil, Algeria | PBD RSM | Colloidal chitin: 20.0 Yeast extract: 0.25 Data syrup: 4.7 K2HPO4/KH2PO4: 1.81 | Temperature: 40 °C pH: natural Rotary speed: 150 rpm Time: 7 days | 26.38 |
| Streptomyces pratensis KLSL55 [21] | Soil, India | OFAT | Colloidal chitin: 15 Fructose: 12.5 KNO3: 5 Mn2+: 0.5 | Temperature: 40 °C pH: 8.0 Rotary speed: 160 rpm Time: 2 days | 14.3 |
| Humicola grisea ITCC 10360.16 [22] | Desert soil, India | PBD RSM | Chitin: 7.49 Colloidal chitin: 4.91 Yeast extract: 5.5 KCl: 0.19 NH4Cl: 1.0 MgSO4⋅7H2O: 0.2 KH2PO4: 0.68 K2HPO4: 0.87 | Temperature: 45 °C pH: 6.5 Rotary speed: 150 rpm Time: 8 days | 1.43 |
| Cohnella sp. A01 [23] | Wastewater, Iran | OFAT OD | Colloidal Chitin: 15 NH4NO3: 5 KH2PO4: 0.7 NaCl: 1.7 | Temperature: 60 °C pH: 6.5 Rotary speed: 180 rpm Time: 3 days | N.M. |
| Serratia marcescens JPP1 [24] | Peanut hulls, China | PBD RSM | Colloidal chitin: 12.7 Glucose: 7.34 Peptone: 5.0 (NH4)2SO4: 1.32 MgSO4⋅7H2O: 0.5 K2HPO4: 0.7 | N.M. | 2.1 |
| Stenotrophomonas maltophilia [25] | Soil, India | PBD RSM | Colloidal chitin: 4.94 Maltose: 5.56 Yeast extract: 0.62 KH2PO4: 1.33 MgSO4⋅7H2O: 0.65 | N.M. | N.M. |
| Factors | Variables |
|---|---|
| Time (days) | 1, 2, 3, 4, 5, 6, 7, 8, 9, 10, 11, 12, 13, 14, 15 |
| Carbon source | glycerol, glucose, ribose, mannose, fructose, sucrose, maltose, starch |
| Nitrogen source | peptone, CH3COONH4, (NH4)2SO4, KNO3, NH4Cl |
| Glucose (g L−1) | 5, 10, 15, 20 |
| Peptone (g L−1) | 1, 2, 3, 4, 5, 10 |
| Chitin (g L−1) | 5, 10, 15, 20 |
| Temperature (°C) | 15, 20, 25, 30, 35, 40 |
| pH | 5.0, 6.0, 6.5, 7.0, 7.5, 8.0, 9.0 |
| Shaking speed (rpm) | 100, 150, 200, 250 |
| Levels | Glucose (g L−1) | Peptone (g L−1) | Chitin (g L−1) | Mg2+ (mM) |
|---|---|---|---|---|
| 1 | 5 | 1 | 5 | 1 |
| 2 | 10 | 2 | 10 | 5 |
| 3 | 15 | 3 | 15 | 10 |
© 2019 by the authors. Licensee MDPI, Basel, Switzerland. This article is an open access article distributed under the terms and conditions of the Creative Commons Attribution (CC BY) license (http://creativecommons.org/licenses/by/4.0/).
Share and Cite
Liu, K.; Ding, H.; Yu, Y.; Chen, B. A Cold-Adapted Chitinase-Producing Bacterium from Antarctica and Its Potential in Biocontrol of Plant Pathogenic Fungi. Mar. Drugs 2019, 17, 695. https://doi.org/10.3390/md17120695
Liu K, Ding H, Yu Y, Chen B. A Cold-Adapted Chitinase-Producing Bacterium from Antarctica and Its Potential in Biocontrol of Plant Pathogenic Fungi. Marine Drugs. 2019; 17(12):695. https://doi.org/10.3390/md17120695
Chicago/Turabian StyleLiu, Kezhen, Haitao Ding, Yong Yu, and Bo Chen. 2019. "A Cold-Adapted Chitinase-Producing Bacterium from Antarctica and Its Potential in Biocontrol of Plant Pathogenic Fungi" Marine Drugs 17, no. 12: 695. https://doi.org/10.3390/md17120695
APA StyleLiu, K., Ding, H., Yu, Y., & Chen, B. (2019). A Cold-Adapted Chitinase-Producing Bacterium from Antarctica and Its Potential in Biocontrol of Plant Pathogenic Fungi. Marine Drugs, 17(12), 695. https://doi.org/10.3390/md17120695
